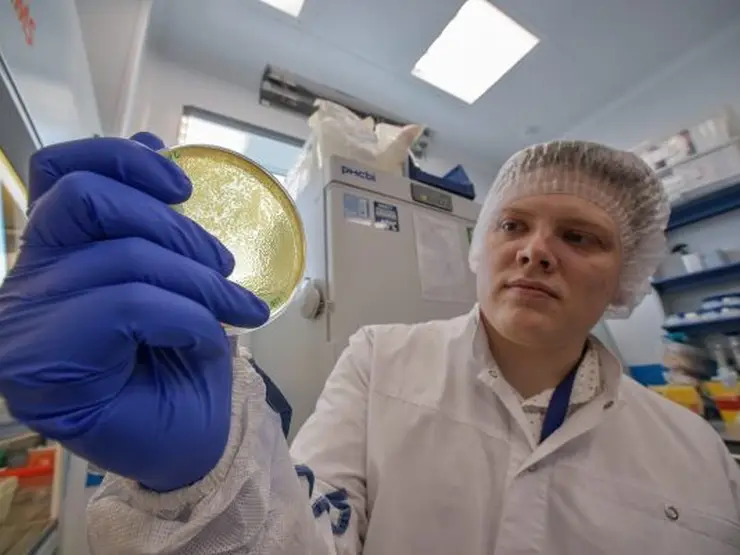
-

© 2002 — 2026 «Сибирское Агентство Новостей»
Возрастная категория Интернет-сайта 18 +
Вся информация, размещенная на данном ресурсе, предназначена только для персонального использования и не подлежит дальнейшему воспроизведению или распространению, иначе как со ссылкой на sibnovosti.ru.
Наименование сетевого издания: Сибирское Агентство Новостей
Учредитель: Общество с ограниченной ответственностью «Сибирское агентство новостей»
И.О. главного редактора: Ершов Сергей Александрович. Адрес электронной почты и номер телефона редакции: sibnovosti@mkrmedia.ru +7 (391) 223-78-48
Знак информационной продукции: 18 +
Сетевое издание зарегистрировано Роскомнадзором, Свидетельство о регистрации Эл № ФС77-61356 от 07.04.2015
По вопросам размещения рекламы обращайтесь: sibnovostiPR@mkrmedia.ru +7 (391) 219-16-19
По вопросам сотрудничества обращайтесь: sibnovostiNEWS@mkrmedia.ru
На информационном ресурсе применяются рекомендательные технологии (информационные технологии предоставления информации на основе сбора, систематизации и анализа сведений, относящихся к предпочтениям пользователей сети Интернет, находящихся на территории Российской Федерации).
Правила применения рекомендательных технологий в виджетах рекламно-обменной сети «СМИ2», размещенных на сайте sibnovosti.ru
Политика обработки персональных данных в ООО «Сибирское агентство новостей»
Сайт работает на Интернет-Платформе для СМИ MoreSMI.ru